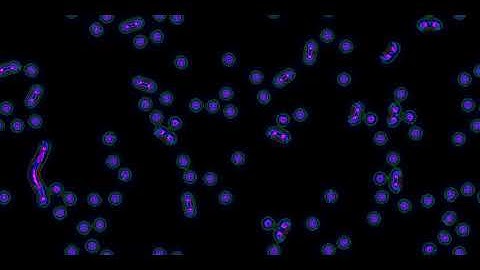
Gliders pushing orbs in a Cellular Automaton

⬇ DOWNLOAD NOW
Jika muncul iklan pop-up, tutup lalu klik tombol kembali
Download lagu Cellular Automaton forms many gliders from constrained wavefronts secara gratis hanya untuk keperluan promosi. Dukung artis favorit kamu dengan membeli musik original di iTunes atau platform resmi lainnya.
 Cellular Automaton forms Wave-Gliders, which form Chainlinks
Cellular Automaton forms Wave-Gliders, which form Chainlinks Cellular Automaton forms many temporary short-range gliders
Cellular Automaton forms many temporary short-range gliders Gliders pushing orbs in a Cellular Automaton
Gliders pushing orbs in a Cellular Automaton![[1080p, 60fps] Cellular Automaton with long, stable wave-gliders](https://i.ytimg.com/vi/B-bE_tBZMEI/hq720.jpg?sqp=-oaymwE9COgCEMoBSFryq4qpAy8IARUAAAAAGAElAADIQj0AgKJDeAHwAQH4Af4JgALQBYoCDAgAEAEYciBaKCgwDw==&rs=AOn4CLC7PycvAOAcBtVMnXvTAWitYJ7lWQ) [1080p, 60fps] Cellular Automaton with long, stable wave-gliders
[1080p, 60fps] Cellular Automaton with long, stable wave-gliders Cellular Automaton that forms manipulable chains
Cellular Automaton that forms manipulable chains Glider found in a 9x9 Totalistic Cellular Automaton
Glider found in a 9x9 Totalistic Cellular Automaton These Cellular Automaton gliders are doing flips - Combination Ruleset with Conway's
These Cellular Automaton gliders are doing flips - Combination Ruleset with Conway's![[1080p] Cellular Automaton forms partitions](https://i.ytimg.com/vi/BV7czfBDY2A/hq720.jpg?sqp=-oaymwE9COgCEMoBSFryq4qpAy8IARUAAAAAGAElAADIQj0AgKJDeAHwAQH4Af4JgALQBYoCDAgAEAEYGSATKH8wDw==&rs=AOn4CLBEq3UZEk9vCkThaKw7vqGHI5Zv7A) [1080p] Cellular Automaton forms partitions
[1080p] Cellular Automaton forms partitions